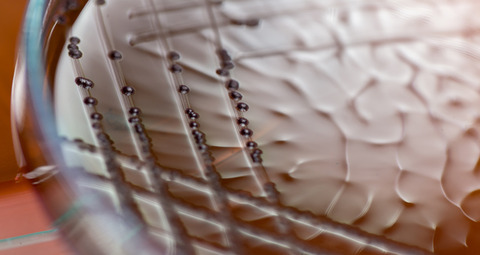

E.coli engineered to consume CO2
28 Nov 2019
Synthetic biologists have engineered an autotrophic form of bacteria.
The Israeli researchers’ form of Escherichia coli, or E.coli, consumes CO2 for energy instead of sugars. The research, which has been published in the journal Cell, could provide carbon neutral bioproduction.
Senior author Ron Milo at the Weizmann Institute of Science in Rehovot, Israel, said: "Our main aim was to create a convenient scientific platform that could enhance CO2 fixation, which can help address challenges related to sustainable production of food and fuels and global warming caused by CO2 emissions.
"Converting the carbon source of E. coli, the workhorse of biotechnology, from organic carbon into CO2 is a major step towards establishing such a platform."
The team grew the microbes in chemostats with a limited supply of the sugar xylose – a source of organic carbon – to inhibit heterotrophic pathways. The strain instead harvested energy from formate, a one-carbon compound, and was contained in an atmosphere composed of 10% CO2.
While the team were able to complete a trophic change in approximately 200 days, the consumption of formate by bacteria was found to release more CO2 than is consumed through carbon fixation.
However, the technique could form the basis of future carbon neutral energy sources after further research into its scalability for industrial use.
First author Shmuel Gleizer said: “Teaching a gut bacterium to do tricks that plants are renowned for was a real long shot… in the end the relatively small number of genetic changes required to make this transition was surprising."